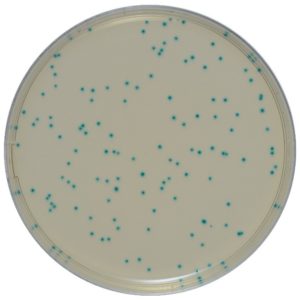

Экспресс-тест для определения количества стафилококков позволяет сократить время, затрачиваемое на проведение лабораторных исследований, по сравнению с классическим чашечным методом и коагулазным тестом, аналогичными по своим характеристикам. Точный результат может быть получен всего за 22 часа. Это способствует повышению производительности и снижению расходов на персонал
Способ применения:
- Инокуляция: добавьте образец под верхнюю пленку тест-пластины
- Инкубирование: поместите тест-пластину в инкубатор. Благодаря продуманному дизайну тест-пластины размещаются в инкубаторе очень компактно
- Подсчет производится с использованием рештки, нанесенной на пластину. Золотистый стафилококк образует отчетливые колонии красно-фиолетового цвета. При наличие высокого уровня фоновой флоры диски для подтверждения (арт. 6493) помогут выделить стафилококк среди других колоний
Цена за коробку
Минимальный заказ — 1 коробка
25 шт. в пакете, 2 пакета в упаковке, 10 упаковок в коробке (500 шт./кор.)

Отзывов пока нет.